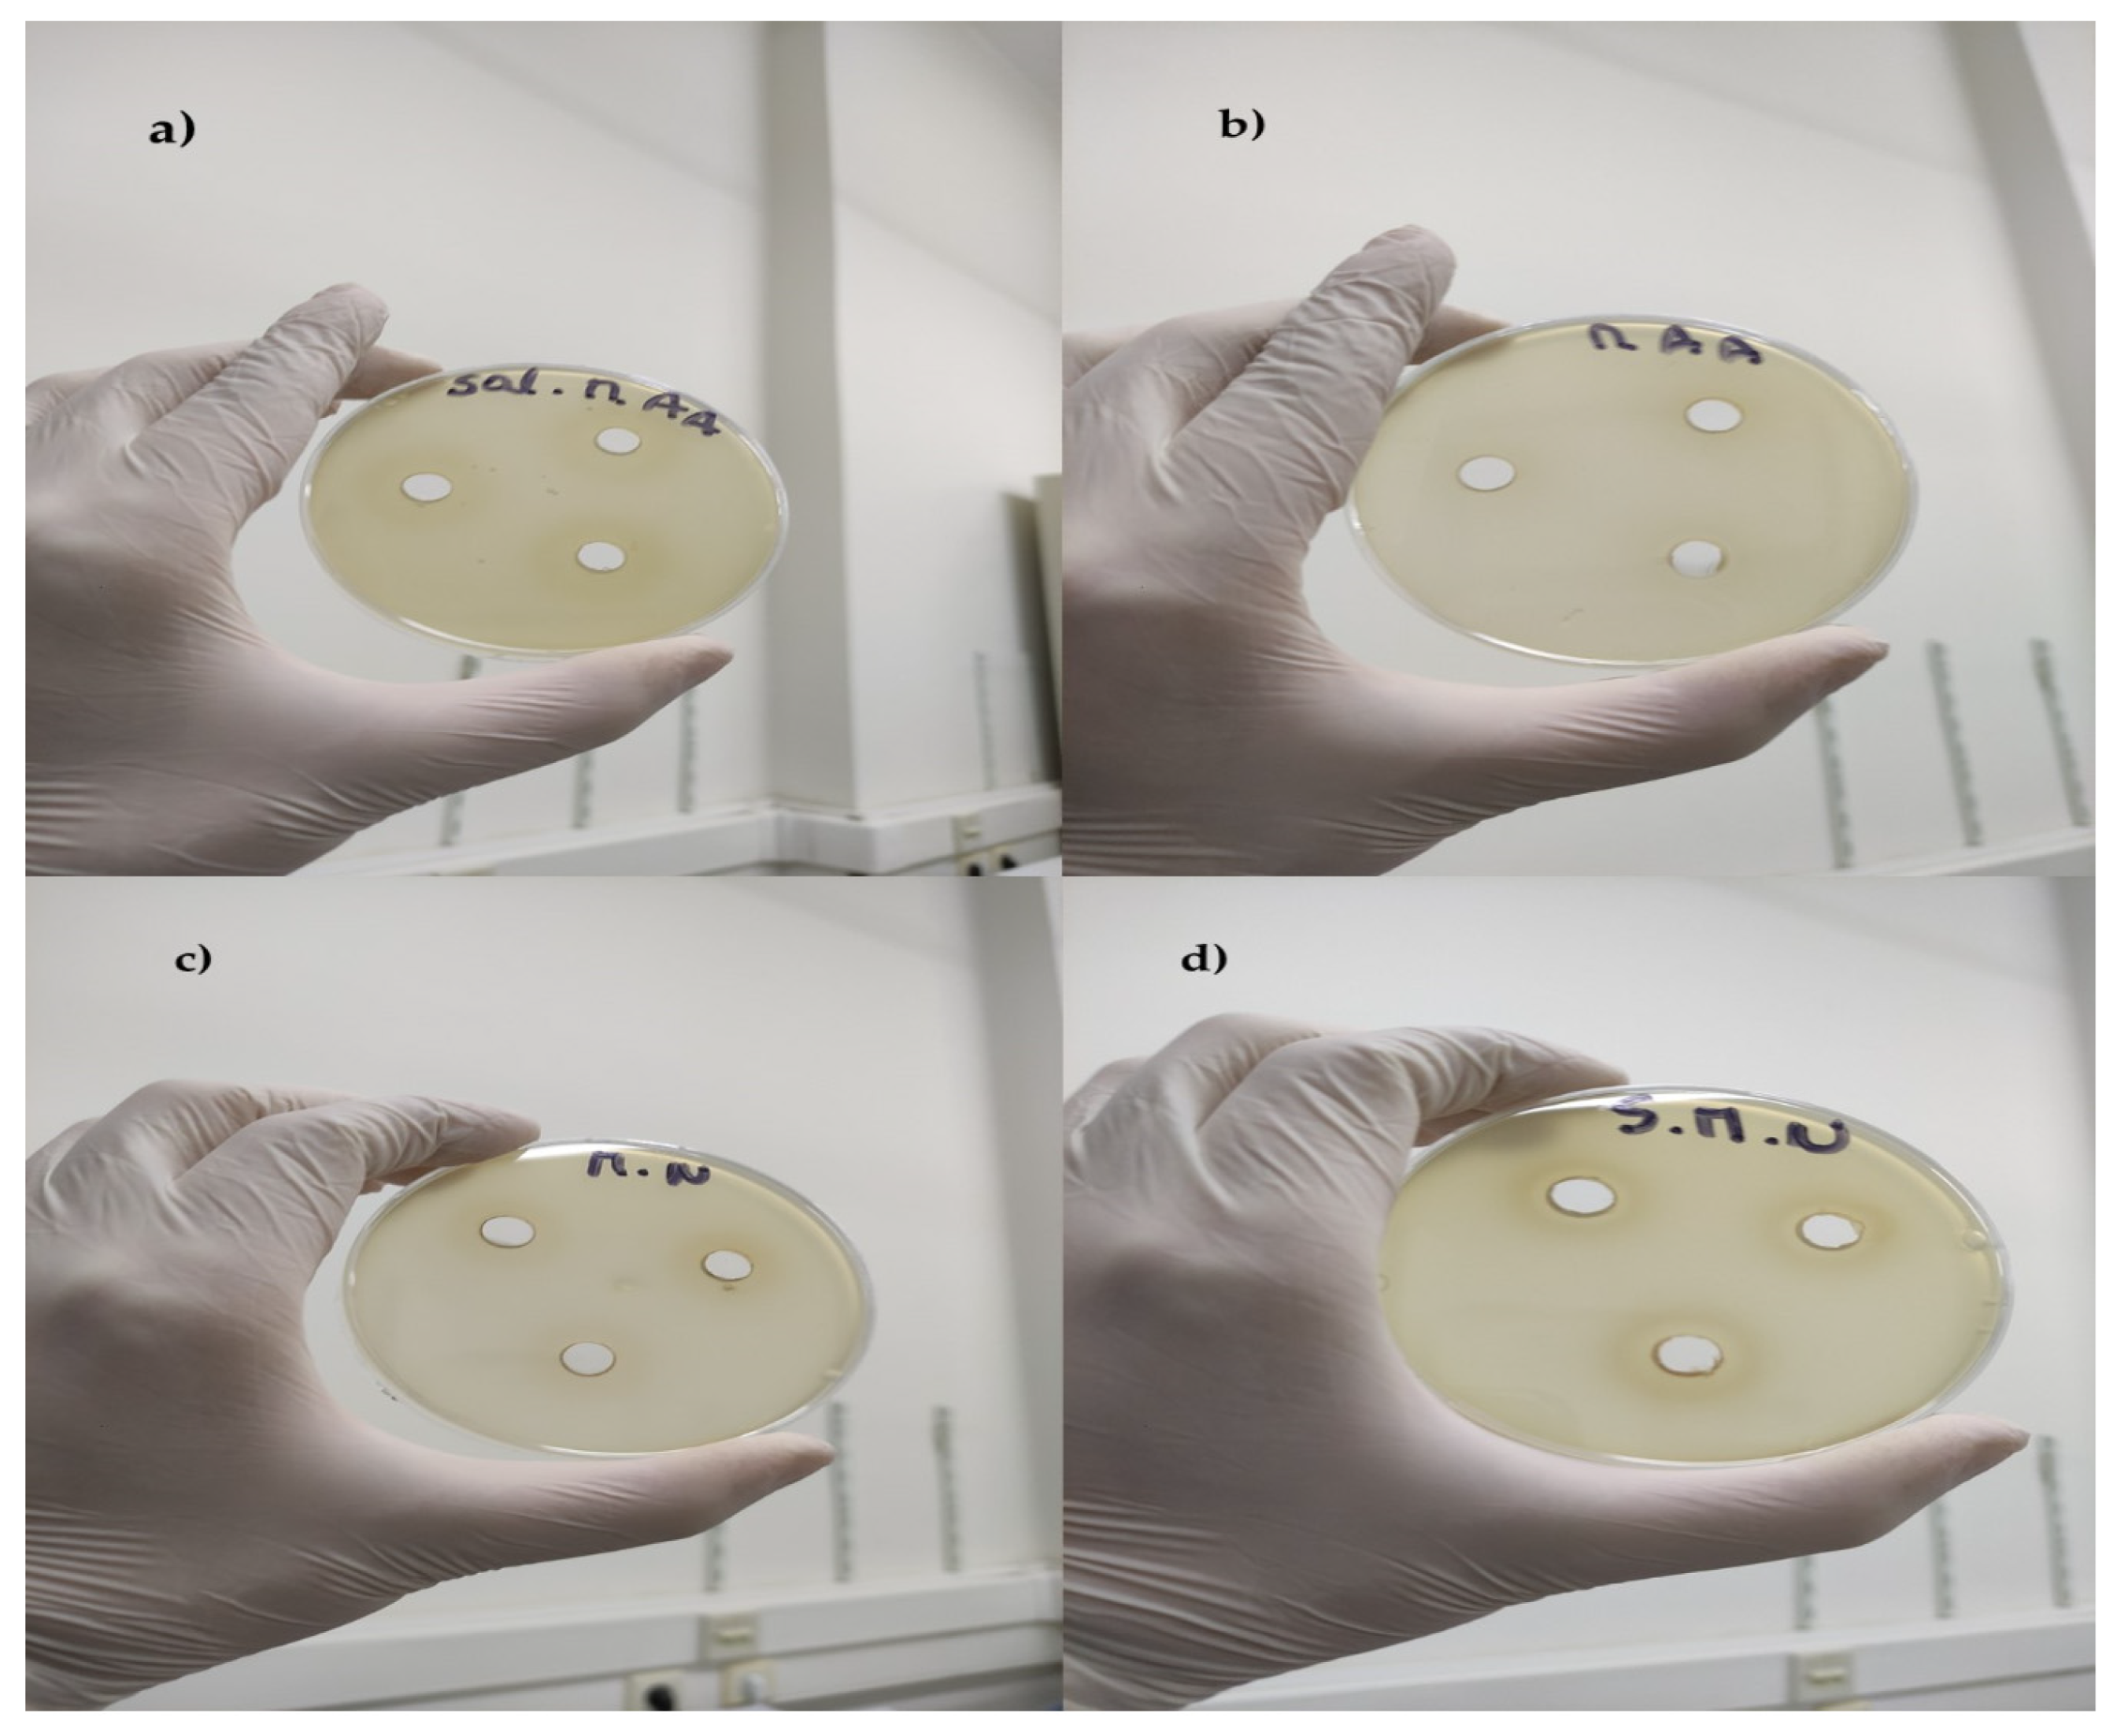
Separations 12 00151 g001

Abstract
The present study aimed to investigate Greek Kollitsida root samples from different geographical regions based on physicochemical and antibacterial analyses. For this purpose, samples were treated with different solvents, deionized water (solvent A) and ethanol of grape origin (solvent B), to monitor if the physicochemical and phytochemical parameter values can be affected by the type of solvent. Results showed that the extraction solvent affected the physicochemical and phytochemical profile of Kollitsida. In addition, the aqueous and ethanolic extracts showed antibacterial activity against Salmonella typhimurium and Staphylococcus aureus, which was also affected by the geographical origin of Kollitsida samples. Finally, the application of multivariate analysis on the data obtained using deionized water or ethanol of grape origin as an extraction solvent for the analyses classified samples according to their geographical origin by 100%, using the cross-validation method of linear discriminant analysis. The study brings new knowledge regarding the physicochemical, phytochemical, and antibacterial profiles, along with the authenticity, of Greek Kollitsida.
1. Introduction
Arctium lappa L. is commonly known as greater burdock, edible burdock, lappa, beggar’s buttons, thorny burr, happy major, or Kollitsida in Greek. The plant originates from Eurasia and belongs to the family Asteraceae. It has also become an invasive weed of high-nitrogen soils in North America, Australia, and other regions, including the Mediterranean zone, Russia, India, China, Taiwan, and Japan. It is naturalized almost everywhere and is usually found in disturbed areas, especially in soil rich in humus and nitrogen, preferring full sunlight [1]. Kollitsida is an herb known since ancient times. Since the first century AD, Dioscorides refers to Kollitsida and its medicinal and therapeutic properties, and it was used in traditional Chinese medicine [2]. Among the reported health benefits, we must consider that Kollitsida has also been used as a powerful liver tonic herb. Moreover, it has exceptional results against diabetes mellitus and obesity, while it is choleretic, diuretic, and is used to heal different skin diseases (acne, thrush, eczema). As an excellent diuretic, it helps eliminate the body’s waste materials and increases the secretion of bile so that fatty foods can be better digested. It is also a blood purifier, and its boiled leaves help heal wounds. Its root is also recommended for rheumatism, high blood pressure, and skin diseases such as herpes and lichen, while it is also useful in pulmonary catarrh as well as a laxative [3]. Extracts prepared from the different parts of the Kollitsida plant possess various biological activities and pharmacological functions [4,5], including antioxidant, anti-inflammatory, anticancer, antidiabetic, antimicrobial, antiviral, anti-allergic, antiulcer, antitubercular, anti-sterility, angiostrongyliasis, gastroprotective, anti-esoteric, hepatoprotective, anti-cytotoxic, and anti-acne effects [2,6].
Kollitsida contains essential oils and resin. Specifically, the root contains essential oil and up to 45% inulin, as well as potassium salts, starch, and other polysaccharides [7], a considerable amount of iron, vitamin B, sulfur, and calcium. The seeds of the plant are bitter and astringent and contain an oil and a glycoside, arctiin [8]. The leaves of the plant contain potassium carbonate and nitrate, as well as various other salts. It should be noted that boiling water removes all the main components of the leaves, the decoction of which takes on a greenish color. Kollitsida also consists of carbohydrates, proteins, volatile oils, plant sterols, and tannins. The principal biologically active compounds in Kollitsida roots comprise volatile compounds, tannin, β-eudesmol, caffeic acid, chlorogenic acid, inulin, trachelogenin, sitosterol-β-D-glucopyranoside, lappaol, terpenes, polyynes, arctiin, arctigenin, and diarctigenin [6,8].
On the other hand, the determination of the geographical origin of food products is a very complicated procedure. There are many factors that can affect the characterization of the geographical origin of food products, such as climate, soil, cropping pattern, storage, handling, etc. Generally, the analytical approaches for the discrimination of geographical origin of foods can include (i) mass spectrometry techniques (i.e., isotope ratio mass spectrometry [9], inductively coupled plasma mass spectrometry [10], proton transfer reaction mass spectrometry, gas chromatography coupled to mass spectrometry [11,12]), (ii) spectroscopic techniques (such as nuclear magnetic resonance spectroscopy, infrared spectroscopy, near-infrared spectroscopy, atomic spectroscopy, Raman spectroscopy) combined with chemometrics methods to determine the geographical origin of food samples [13,14,15,16,17], (iii) separation techniques, including high performance liquid chromatography [18], gas chromatography [19], capillary electrophoresis [20], and (iv) other techniques, including sensor technology.
There is a lack of information in the literature regarding the physicochemical, phytochemical, and antimicrobial profile of Kollitsida cultivated in Greece. Therefore, the present study aimed to investigate the phytochemical and antimicrobial profile of Kollitsida from different geographical regions in Greece. To optimize the extraction procedure of phytochemicals, different solvents (deionized water and ethanol of grape origin) were used, and the best solvent was finally selected as the target solvent for the research hypothesis. To the best of our knowledge, there are no published articles with this hypothesis, making this the novelty of our study.
2. Materials and Methods
2.1. Preparation of Kollitsida Fine Powders
Greek Kollitsida (Arctium lappa L.) roots from 4 different geographical regions (Patra, Ioannina, Heraklion, and Alexandroupoli) were purchased from local stores. Afterward, the samples were brought to the laboratory and then pulverized using a blender (Rohnson, Heavy duty, Prague, Czech Republic) to obtain the fine powder used in this study.
2.2. Chemicals and Reagents
Follin–Ciocalteu reagent was purchased from Sigma-Aldrich (Darmstadt, Germany). Sodium carbonate (Na2CO3) and acetate buffer (CH3COONa × 3H2O) were purchased from Penta (Prague, Czech Republic). Absolute ethanol (CH3CH2OH) and phenolphthalein (C20H10O4) were purchased from Merck (Darmstadt, Germany), 2,2-Diphenyl-1-picrylhydrazyl (DPPH.) was purchased from TCI (Tokyo, Japan), gallic acid (3,4,5-trihydrobenzoic acid), 99% isolated from Rhus chinensis Mill., was purchased from JNK Tech. Co. (Seongnam, Republic of Korea), and sodium hydroxide (NaOH) was purchased from Lach-Ner (Zagreb, Croatia).
2.3. Extraction of Phytochemicals
The phytochemicals of Kollitsida were extracted using different solvents: deionized water (solvent A) and ethanol obtained through the distillation of dry white wine (solvent B). Ethanol of grape origin was selected as a solvent due to its natural bi-polar phase (aqueous and organic), resulting in better extraction of phytochemicals [21]. Moreover, it can be considered an eco-friendly solvent for the environment (green solvent) as scientists tend to avoid exposure to synthetic chemicals. For the distillation of ethanol (at 79 °C), 300 mL of dry white wine was used. The distillation of dry white wine stopped after collecting 200 mL of ethanol. After that, 5 g of each powder was diluted with 50 mL of each solvent in a plastic tube and vortexed for 5 min. Finally, the samples were out in a dark place at room temperature for 24 h. The next day, the extracts were filtered using filter paper, and the samples were analyzed.
2.4. Determination of Total Phenolic Content
The total phenolic content in Kollitsida was determined following the method of Lazaridis et al. [21]. Firstly, 0.2 mL of the samples was placed in Falcon tubes. Thereafter, 2.5 mL of deionized water and 0.25 mL of the Folin reagent were added. The mixture was left in a dark place for 2–3 min, and then, 0.5 mL of sodium carbonate was added. The mixture was filled to the mark (5 mL) with deionized water and placed again in a dark place for 2 h at room temperature. After 2 h, the absorbance was measured at λ = 760 nm with a UV/VIS spectrophotometer (UV-1280, Kyoto, Japan). Results were expressed as milligrams of gallic acid equivalents per liter using a standard calibration curve in the range of 0–500 mg/L:
Each sample was analyzed in triplicate (n = 3).
2.5. Determination of Antioxidant Activity
The standard solution of DPPH was prepared in a volumetric flask by dissolving 0.004 g of DPPH in 100 mL of absolute ethanol. The standard solution was wrapped with aluminum foil and stirred in a vortex apparatus. The antioxidant activity was calculated with the following equation:
A0: initial absorbance of DPPH solution; At: absorbance of DPPH after the reaction with the antioxidants of Kollitsida.
To calculate the antioxidant activity, 0.1 mL of Kollitsida sample, 1.9 mL of DPPH solution, and 1 mL of acetate buffer (100 mM) were placed in a cuvette, following the method of Kitsios et al. [22]. The absorbance was measured at λ = 517 nm every 30 min until the reaction reached a plateau.
2.6. Determination of Caffeic Acid Content
For the determination of the caffeic acid content, 3 mL of Kollitsida samples were placed in a cuvette, and the absorbance was measured at λ = 325 nm. Results were expressed as milligrams of caffeic acid per liter according to the following calibration curve in the range of 0–11 mg/L [21]:
Each sample was analyzed in triplicate (n = 3).
2.7. Determination of Quercetin Content
For the determination of quercetin content, 3 mL of the Kollitsida sample was transferred to a cuvette, and the absorbance was measured at λ = 376 nm using the spectrophotometer mentioned before. Results were expressed as milligrams of quercetin per liter according to the following calibration curve in the range of 0–20 mg/L [21]:
Each sample was analyzed in triplicate (n = 3).
2.8. Determination of pH
For the determination of pH, 20 mL of each sample was transferred to a beaker, and then a portable pH-meter (pHEP+ HI9808, HANNA Instruments, Athens, Greece) was immersed in the sample. Results were expressed as pH values a 20 °C. Each sample was analyzed in triplicate (n = 3).
2.9. Determination of Color Parameters
The color parameters of Kollitsida samples were measured after determining the absorbance values a λ = 420 nm (yellow color tones, YCT), λ = 520 nm (blue color tone, BCT), and λ = 620 nm (red color tones, RCT) [21]. For the determination of color, the following equations:
where CI: color intensity A420 + A520 + A620. The color tones were expressed as percentages. Each sample was analyzed in triplicate (n = 3).
2.10. Determination of Oxalic Acid
To determine oxalic acid content, a method developed in our laboratory was carried out. Firstly, 45 mL of deionized water and 5 mL of Kollitsida sample were brought into a conical flask. The sample was titrated with sodium hydroxide (0.1 M), using phenolphthalein as the endpoint indicator. Results were expressed as milligrams of oxalic acid per 100 g of sample, considering that 1 mL of NaOH corresponds to 4.50 mg of oxalic acid. Each sample was analyzed in triplicate (n = 3).
2.11. Determination of Antibacterial Activity
The antibacterial activity of Kollitsida samples was tested according to the method described by Kokkosi et al. [23]. One Gram-negative Salmonella enterica subspecies enterica serovar typhimurium (NCTC 12023) and one Gram-positive Staphylococcus aureus (NCTC 6571) foodborne pathogens were obtained to test the antibacterial activity of each Kollitsida extract (solvent A and solvent B) from each geographical region. Salmonella typhimurium bacteria were purchased from LGC Standards Proficiency Testing (Chamberhall Green Bury, Lancashire, UK) in the form of disc-shaped VitroidsTM, and Staphylococcus aureus bacteria were purchased from Supelco® Analytical Products (Bellefonte, PA, USA) in the form of easy-tabTM pellets. According to the 0.5 McFarland standard, approx. 1.5 × 108 CFU/mL of each bacterial strain was transferred in 3 mL of 0.85% maximum recovery diluent (MRD) (Merck, Darmstadt, Germany), and 0.5 mL of the suspended bacteria was placed in 20 mL MH agar (Oxoid, Basingstoke, UK) and poured into Petri dishes. Finally, 3 punctures were made in each Petri dish with a diameter of 6 mm, using a sterile cork borer, and 0.5 mL of each Kollitsida extract was added, and the dishes were incubated at 37 °C for 24 h. The inhibition zone diameter was measured using a Vernier caliper with 0.1 mm accuracy. Results were expressed as the average ± standard deviation values of nine replicates. Finally, control samples (positive or negative test) using deionized water and ethanol of grape origin were tested against Salmonella typhimurium and Staphylococcus aureus.
2.12. Statistical Analysis
Data were subjected to a one-way analysis of variance (ANOVA) to indicate if there were statistically significant (p < 0.05) differences between the average values of each determined parameter concerning the geographical origin of Kollitsida. Post hoc analysis with Tukey’s honestly significant difference (HSD) test was also carried out to check the statistically significant (p < 0.05) differences between pairs of sample regions. To monitor the impact of geographical origin on the determined parameters of Kollitsida and classify samples according to geographical origin, multivariate analysis of variance (MANOVA) and linear discriminant analysis (LDA) were also implemented [24]. Pearson’s correlation (−1 ≤ r ≤ + 1) bivariate statistics was carried out at the confidence level p < 0.05 to find positive or negative correlations between phytochemical content (total phenolic content, caffeic acid content, quercetin content) and inhibition zones of Salmonella typhimurium and Staphylococcus aureus concerning the extraction solvent of Kollitsida samples (deionized water or ethanol of grape origin). Statistical analysis was conducted using the SPSS software (v. 28, IBM, Armonk, NY, USA, 2021).
3. Results
3.1. Physicochemical Parameters and Phytochemical Content of Greek “Kollitsida’’ Extracted with Deionized Water
Table 1 shows the parameters determined using deionized water as a solvent according to the geographical origin of the Kollitsida samples. Remarkably, samples showed significant (p < 0.05) variations in the determined parameters concerning their geographical origin.
Table 1.
Physicochemical parameters and phytochemical content of Greek “Kollitsida’’ extracted with deionized water.
The highest pH values were recorded in Kollitsida samples from Patra, whereas the lowest values were recorded in samples from Alexandroupoli. On the other hand, the highest oxalic acid content was observed in samples from Alexandroupoli, and the lowest in samples from Heraklion. What is remarkable is that all samples had a high mineral content, as indicated by the determined ash values. In addition, the color tones (YCT, BCT, and RCT) showed fluctuations in their values according to the geographical origin of the samples. Similarly, the highest caffeic acid content was determined in samples from Alexandroupoli, followed by those from Patra, Heraklion, and Ioannina. This was not the case in the quercetin content, where the highest quercetin content was recorded in samples from Patra, followed by those of Heraklion and Ioannina, while in samples from Alexandroupoli, quercetin was not identified. This is a finding that requires future research. On the other hand, total phenolic content was the highest in samples from Alexandroupoli, followed by those from Heraklion, Ioannina, and Patra. Finally, a considerable antioxidant activity was observed in all samples, with the highest values being recorded in samples from Alexandroupoli, followed by those of Ioannina, Patra, and Heraklion. The total phenolic content was positively correlated (r = 0.781, p = 0.003) with caffeic acid content and negatively correlated (r = −0.893, p < 0.001) with quercetin content.
3.2. Physicochemical Parameters and Phytochemical Content of Greeκ “Kollitsida’’ Extracted with Ethanol of Grape Origin
Table 2 shows the parameters determined using ethanol of grape origin as a solvent according to the geographical origin of the Kollitsida samples. As in the previous case, samples also showed significant (p < 0.05) variations in the determined parameters with respect to their geographical origin.
Table 2.
Physicochemical parameters and phytochemical content of Greek “Kollitsida’’ extracted with ethanol of grape origin.
In this case, the highest pH values were recorded in Kollitsida samples from Patra, whereas the lowest values were recorded in samples from Herakleion. On the other hand, the highest oxalic acid content was observed in samples from Alexandroupoli, and the lowest in samples from Patras. In addition, the color tones (YCT, BCT, and RCT) showed fluctuations in their values according to the geographical origin of the samples. Similarly, the highest caffeic acid content was determined in samples from Alexandroupoli, followed by those from Patras, Herakleion, and Ioannina. This was not the case in the quercetin content, where the highest quercetin content was recorded in samples from Heraklion, followed by those of Patra and Ioannina, while in samples from Alexandroupolis, quercetin was not identified. On the other hand, total phenolic content was the highest in samples from Alexandroupoli, followed by those from Herakleion, Ioannina, and Patra. Finally, a considerable antioxidant activity was observed in all samples, with the highest values being recorded in samples from Heraklion, followed by those of Alexandroupoli, Ioannina, and Patra. Similarly, the total phenolic content was positively correlated (r = 0.898, p < 0.001) with caffeic acid content and negatively correlated (r = −0.111, p = 0.732) with quercetin content.
3.3. Antimicrobial Activity of Greek “Kollitsida’’ Samples According to Geographical Origin
Table 3 shows the antimicrobial activity of Kollitsida extracts from different regions against Staphylococcus aureus and Salmonella typhimurium. Remarkably, both extracts (deionized water and ethanol of grape origin) showed a considerable antibacterial activity, whereas the control tests showed no inhibition zones. As a result, the inhibition zones on Greek Kollitsida samples are due to the extracted phytochemicals. Figure 1 shows the inhibition zones of Kollitsida extracts with ethanol of grape origin and deionized water from Patra against Salmonella typhimurium and Staphylococcus aureus. The highest inhibition zone in Salmonella typhimurium was recorded for Kollitsida samples from Alexandroupoli when ethanol of grape origin was used for the extraction. In the case of using deionized water as the extraction solvent, the highest inhibition zone was recorded for Kollitsida samples from Ioannina. Regarding Staphylococcus aureus, the highest inhibition zone was recorded again for Kollitsida samples from Alexandroupoli when ethanol of grape origin was used for the extraction. In the case of using deionized water as the extraction solvent, the highest inhibition zone was recorded for Kollitsida samples from Heraklion.
Table 3.
Antibacterial activity of aqueous and ethanolic extracts of Kollitsida according to the geographical origin.
Figure 1.
Inhibition zones of Kollitsida extracts with ethanol of grape origin from Patra against (a) Salmonella typhimurium and (b) Staphylococcus aureus. Inhibition zones of Kollitsida extracts with deionized water from Patra against (c) Salmonella typhimurium and (d) Staphylococcus aureus.
To further search for the antimicrobial activity of Kollitsida extracts against Salmonella typhimurium and Staphylococcus aureus, Pearson’s correlation was applied between the inhibition zones and the total phenolic content, caffeic acid content, and quercetin content for each extraction solvent. In the case of deionized water, the total phenolic content was positively correlated (r = 0.757, p = 0.004) with the inhibition zones of Salmonella typhimurium. Similarly, caffeic acid content was positively correlated (r = 0.236, p = 0.460), whereas a negative correlation (r = −0.517, p = 0.085) was obtained for quercetin content and the inhibition zones of Salmonella typhimurium. Concerning Staphylococcus aureus, the respective correlations were as follows: r = −0.195, p = 0.544 for the total phenolic content, r = 0.276, p = 0.386 for caffeic acid content, and r = −0.236, p = 0.459 for quercetin content. For the extracts of Kollitsida prepared with ethanol of grape origin, the inhibition zones of Salmonella typhimurium were positively correlated with the total phenolic content (r = 0.889, p < 0.001), with caffeic acid content (r = 0.896, p < 0.001), and with quercetin content (r = 0.133, p = 0.680). Finally, the inhibition zones of Staphylococcus aureus were positively correlated with the total phenolic content, having r = 0.447, p = 0.145; with caffeic acid content, having r = 0.791, p = 0.002; and with quercetin content, having r = 0.100, p = 0.757. It is also important to stress that limited studies in the literature have attempted to correlate the phenolic compounds’ extracts with inhibition zones obtained for specific microorganisms. In addition, the correlations obtained show that phenolic compounds and especially caffeic acid of Kollitsida extracts have a considerable antimicrobial activity in both extraction solvents: deionized water and ethanol of grape origin. These findings are in agreement with those of Kokkosi et al. [23].
3.4. Geographical Origin Recognition of Greek “Kollitsida’’ According to Geographical Origin
For the geographical origin recognition of Kollitsida samples, each data set of parameters with respect to the extraction solvent was subjected to MANOVA and LDA. Using both solvents, samples were classified 100% based on the cross-validation method (Figure 2 and Figure 3).
Figure 2.
Classification of Greek Kollitsida samples according to the geographical origin based on physicochemical and phytochemical parameters using LDA and deionized water as an extraction solvent.
Figure 3.
Classification of Greek Kollitsida samples according to the geographical origin based on physicochemical and phytochemical parameters using LDA and ethanol of grape origin as an extraction solvent.
To avoid an extended article, we present the analytical data of the statistical analysis concerning the extraction of Kollitsida samples with ethanol of grape origin, a less-used solvent in food research. The multivariate hypothesis testing, considering the Pillai’s Trace and Wilks’ Lambda indices, both having an observed power of 1000, showed that there was a significant impact of the geographical origin of Kollitsida samples on their physicochemical and phytochemical parameters. This strong effect is shown by the interval values of Pillai’s Trace and Wilks’ Lambda (Table 4). In principle, the lower the Wilks’ Lambda values, the higher the differences between groups of subjects. In cases where the Wilks’ Lambda value is 0.000, the differences between the studied groups are very clear. The multivariate effect of the analysed samples regarding their physicochemical and phytochemical parameters is shown by the F-value tests. These tests are based on linearly independent pairwise comparisons among the estimated marginal means. Among the 10 determined parameters, 7 showed significant differences (p < 0.05) in their values (Table 5) according to the geographical origin of Kollitsida samples.
Table 4.
Analytical values of MANOVA indices during the multivariate testing of physicochemical and phytochemical parameters determined in Greek Kollitsida samples.
Table 5.
Significant physicochemical and phytochemical parameters related to the geographical origin of Greek Kollitsida samples.
Three discriminant functions were formed that had the statistical metrics given in Table 6, such as eigenvalues, variance (%), cumulative variance (%), canonical correlation, Wilks’ Lambda values, chi-square values, degrees of freedom, and level of significance (p-value). The total variance explained by the three discriminant functions was 100% based on both original and cross-validation methods. In brief, the eigenvalues of the discriminant functions are critical parameters since these provide information on how well the function differentiates the initial groups (i.e., geographical origin of Kollitsida samples). Therefore, the higher the eigenvalue in LDA, the higher the classification rate [24]. The group centroid values shown in Figure 3 are as follows: (55.409, 56.620), (−5.106, −369.437), (−774.675, 154.511), and (724.371, 158.306), for Kollitsida samples from Patra, Heraklion, Ioannina, and Alexandroupoli.
Table 6.
Statistical parameters of LDA.
Table 7 shows that the key physicochemical and phytochemical parameters significantly correlated with the geographical origin of Greek Kollitsida samples. Similarly, Figure 4 shows Fisher’s linear discriminant functions derived by LDA for the geographical origin recognition of Greek Kollitsida samples.
Table 7.
Key physicochemical and phytochemical parameters correlated to the geographical origin of Greek Kollitsida samples.
Figure 4.
Discriminant functions derived by LDA for the geographical origin recognition of Greek Kollitsida samples. TPC: total phenolic content. BCT: blue color tone. RCT: red color tone.
4. Discussion
Limited studies are available in the recent literature that report on conventional physicochemical parameters of Kollitsida, such as acidity, ash, and color. Vanaki et al. [25] reported total acidity values of Iranian aqueous Kollitsida extracts equal to 0.98%, higher than the results of the present study using either deionized water or ethanol of grape origin as a solvent for the extracts. However, in the present study, we determined only the oxalic acid content. The pH values of Kollitsida aqueous extracts determined by Vanaki et al. [26] are in agreement with the results of the present study. Color and ash values have not been reported before for Kollitsida samples according to our knowledge. On the other hand, there is a considerable number of studies in the literature that report on the antioxidant activity, total phenolic content, and individual phenolic compound content of Kollitsida samples with different geographical origins extracted with water or organic solvents [4,5,6,26]. Predes et al. [26] reported that the highest phenolic compound concentrations in Brazilian Kollitsida root extracts were obtained for Soxhlet extraction with dichloromethane (79.45 mg gallic acid/g extract) and ethanol (77.26 mg gallic acid/g extract), whereas the hydroethanolic extract showed a considerable phenolic content (72.61 mg gallic acid/g extract). In addition, the hydroethanolic extracts had considerable amounts of quercetin (18.27 mg/L) and caffeic acid (21.78 mg/L). The authors also reported that the hydroethanolic extracts had a high antioxidant activity, which is in agreement with the results of the present study. Petkova et al. [6] reported that the Bulgarian Kollitsida root extracts obtained using organic solvents (hexane, chloroform, and ethyl acetate) had a considerable total phenolic content and antioxidant activity, whereas no quercetin and caffeic acid were determined. In our case, the phenolics determined either as the total polyphenol content or as caffeic acid and quercetin were affected by the extraction solvent and the geographical origin. Considering the extraction solvent (deionized water), the highest TPC (867.29 ± 1.42 mg GAE/L) and caffeic acid (206.20 ± 0.41 mg/L) values were recorded in Kollitsida samples from Alexandroupoli, whereas quercetin recorded the highest values (102.81 ± 0.48 mg/L) in samples from Patra. Using ethanol of grape origin as an extraction solvent, the highest TPC (881.57 ± 1.43 mg GAE/L) and caffeic acid (202.70 ± 0.21 mg/L) values were recorded again in Kollitsida samples from Alexandroupoli, whereas quercetin recorded the highest values (67.42 ± 0.25 mg/L) in samples from Heraklion. As in the case of physicochemical parameter analysis, there is no study in the literature reporting the phenolic compounds’ content of Greek Kollitsida and the impact of extraction solvents and geographical origin on these contents.
Another critical point to discuss is that data regarding the antibacterial activity of Greek Kollitsida are scarce. Previous studies in the literature have documented the antibacterial activity of Kollitsida extracts against several food pathogens, including Salmonella sp., Escherichia coli, Listeria monocytogenes, Pseudomonas aeruginosa, Proteus vulgaris, Staphylococcus aureus, Bacillus cereus, and Candida albicans [6]. Indeed, Petkova et al. [6] indicated that hexane, chloroform, ethyl acetate, and water extracts of Bulgarian Kollitsida had a considerable antimicrobial activity against the aforementioned pathogens. The ethyl acetate extracts had the highest antimicrobial activity. In another study, the anticancer activity of Brazilian Kollitsida extracts was studied. Hence, the dichloromethanic extracts of Brazilian Kollitsida samples showed selective antiproliferative activity against K562, MCF-7, and 786–0 human cancer cell lines [26]. Moreover, recently, Vanaki et al. [25] supported the effect of aqueous extract of Iranian Kollitsida samples on the survival of Lactobacillus acidophilus La-5 and Bifidobacterium bifidum Bb-12 probiotic bacteria, and sensory and physicochemical properties of synbiotic yogurt were evaluated during 4 weeks of refrigerated storage (4 °C) using this prebiotic compound (Kollitsida extract). The authors reported that the Kollitsida extract can improve nutritional properties and probiotic protection in yogurt during long-term storage, thus presenting an essential option for application in the dairy industry.
Furthermore, regarding the classification of Kollitsida samples according to the geographical origin, we did not find many studies in the literature; this comprises a field of future research. In particular, Funaki et al. [27] classified Kollitsida samples from Japan and China using minerals. The authors reported that using five elements (Na, K, Ca, Ce, and Tl) and linear discriminant analysis, the discrimination accuracy of the samples based on the cross-validation method showed a discrimination accuracy exceeding 93%, in agreement with the results of the present study. Hu et al. [28] classified Chinese and Taiwanese Kollitsida samples using multiple chemometric techniques based on fluorescence spectroscopy data. Partial least squares discriminant analysis (PLS-DA) provided classification accuracy, leading to classification rates ranging between 77.8% and 100%, in agreement with the present results.
Considering the above, an in-depth discussion of the internal reasons for the present experimental results should focus on the parameters accounting for why Kollitsida samples from different regions have significant differences in the chemical composition and antibacterial activity. In our opinion, these findings are related to soil, climate, cultivation practices, and other factors.
5. Conclusions and Future Perspectives
The results of the present study showed that Kollitsida is a plant-based food that possesses high antioxidant activity and the total phenolic content, along with specific physicochemical profiles, which are greatly affected by its geographical origin. The ethanolic extracts of Kollitsida using ethanol of grape origin as an extraction solvent showed antibacterial activity against Salmonella typhimurium and Staphylococcus aureus. Finally, the application of multivariate analysis classified samples according to their geographical origin with 100% accuracy based on the cross-validation method of LDA. The present study brings new knowledge regarding the physicochemical, phytochemical, antibacterial, and authenticity profiles of Greek Kollitsida, given that limited studies are available in the modern literature. However, we must stress that the study can be improved using instrumental methods of analysis such as liquid chromatography coupled to mass spectrometry (LC-MS) or nuclear magnetic resonance (NMR) to identify and quantify phenolic compounds such as arctiin or chlorogenic acid, which are known constituents in Kollitsida. Even though only UV-Vis spectroscopy was used, the results obtained are promising, and a higher number of samples from more regional departments in Greece or from other countries will further strengthen the present findings. In conclusion, a future study could focus on the application of burdock extracts in different foods of plant and animal origin to extend their shelf life. The findings could be very promising for further application of these extracts in the food industry.
Author Contributions
Conceptualization, I.K.K. and D.G.L.; methodology, D.G.L., S.D.G., M.S., V.K.K., N.D.A., V.T. and I.K.K.; software, I.K.K., N.D.A. and V.T.; validation, I.K.K., N.D.A. and V.T.; formal analysis, D.G.L., S.D.G., M.S. and V.K.K.; investigation, D.G.L., S.D.G. and I.K.K. resources, I.K.K. and N.D.A.; data curation, D.G.L., S.D.G., M.S. and V.K.K.; writing—original draft preparation, I.K.K. and D.G.L.; writing—review and editing, I.K.K.; visualization, D.G.L. and I.K.K.; supervision, I.K.K., N.D.A. and V.T.; project administration, I.K.K.; funding acquisition, I.K.K. and N.D.A. All authors have read and agreed to the published version of the manuscript.
Funding
This research received no external funding.
Data Availability Statement
The original contributions presented in this study are included in the article. Further inquiries can be directed to the corresponding author.
Acknowledgments
The authors would like to thank cordially the Department of Research, Innovation, and Entrepreneurship of the University of Patras for the financial support (consumables) of this research study.
Conflicts of Interest
The authors declare no conflicts of interest.
References
- Arctium lappa. Arctium lappa. Germplasm Resources Information Network. Agricultural Research Service, United States Department of Agriculture. Available online: https://www.ars-grin.gov/ (accessed on 8 February 2025).
- Chan, Y.-S.; Cheng, L.-N.; Wu, J.-H.; Chan, E.; Kwan, Y.-W.; Lee, S.M.-Y.; Leung, G.P.-H.; Yu, P.H.-F.; Chan, S.-W. A review of the pharmacological effects of Arctium lappa (burdock). Inflammopharmacology 2010, 19, 245–254. [Google Scholar] [CrossRef] [PubMed]
- Li, Z.; Zhang, Z.; Ding, J.; Li, Y.; Cao, G.; Zhu, L.; Bian, Y.; Liu, Y. Extraction, Structure and Bioactivities of Polysaccharide from Root of Arctium lappa L.: A Review. Int. J. Biol. Macromol. 2024, 265, 131035. [Google Scholar] [CrossRef] [PubMed]
- Liu, H.; Zhang, Y.; Sun, Y.; Wang, X.; Zhai, Y.; Sun, Y.; Sun, S.; Yu, A.; Zhang, H.; Wang, Y. Determination of the Major Constituents in Fruit of Arctium lappa L. By Matrix Solid-Phase Dispersion Extraction Coupled with HPLC Separation and Fluorescence Detection. J. Chromatogr. B 2010, 878, 2707–2711. [Google Scholar] [CrossRef]
- da Silva, L.M.; Allemand, A.; Mendes, D.A.G.B.; dos Santos, A.C.; André, E.; de Souza, L.M.; Cipriani, T.R.; Dartora, N.; Marques, M.C.A.; Baggio, C.H.; et al. Ethanolic Extract of Roots from Arctium lappa L. Accelerates the Healing of Acetic Acid-Induced Gastric Ulcer in Rats: Involvement of the Antioxidant System. Food Chem. Toxicol. 2013, 51, 179–187. [Google Scholar] [CrossRef]
- Petknova, N.; Hambarlyiska, I.; Tumbarski, Y.; Vrancheva, R.; Raeva, M.; Ivanov, I. Phytochemical Composition and Antimicrobial Properties of Burdock (Arctium lappa L.) Roots Extracts. Biointerface Res. Appl. Chem. 2022, 12, 2826–2842. [Google Scholar] [CrossRef]
- Carlotto, J.; Souza, L.M.d.; Baggio, C.H.; Fernanda, M.; Maria-Ferreira, D.; Sassaki, G.L.; Iacomini, M.; Cipriani, T.R. Polysaccharides from Arctium lappa L.: Chemical Structure and Biological Activity. Int. J. Biol. Macromol. 2016, 91, 954–960. [Google Scholar] [CrossRef]
- Hayashi, K.; Narutaki, K.; Nagaoka, Y.; Hayashi, T.; Uesato, S. Therapeutic effect of arctiin and arctigenin in immunocompetent and immunocompromised mice infected with influenza. Biol. Pharm. Bull. 2010, 33, 1199–1205. [Google Scholar] [CrossRef]
- Mekki, I.; Camin, F.; Perini, M.; Smeti, S.; Hajji, H.; Mahouachi, M.; Piasentier, E.; Atti, N. Differentiating the geographical origin of Tunisian indigenous lamb using stable isotope ratio and fatty acid content. J. Food Compos. Anal. 2016, 53, 40–48. [Google Scholar] [CrossRef]
- Gaiad, J.E.; Hidalgo, M.J.; Villafañe, R.N.; Marchevsky, E.J.; Pellerano, R.G. Tracing the Geographical Origin of Argentinean Lemon Juices Based on Trace Element Profiles Using Advanced Chemometric Techniques. Microchem. J. 2016, 129, 243–248. [Google Scholar] [CrossRef]
- Aprea, E.; Carlin, S.; Versini, G.; Märk, T.D.; Gasperi, F. Assessing truffle origin by PTR-MS fingerprinting and comparison with GC-MS for the headspace analysis. In Proceedings of the 3rd International Conference on Proton Transfer Reaction Mass Spectrometry, Obergurgl, Austria, 27 January–1 February 2007; Hansel, A., Märk, T.D., Eds.; University Press: Innsbruck, Austria, 2007; pp. 132–135, ISBN 3902571039. Available online: http://hdl.handle.net/10449/16072 (accessed on 10 April 2025).
- Povolo, M.; Contarini, G.; Mele, M.; Secchiari, P.L. Study on the Influence of Pasture on Volatile Fraction of Ewes’ Dairy Products by Solid-Phase Microextraction and Gas Chromatography-Mass Spectrometry. J. Dairy Sci. 2007, 90, 556–569. [Google Scholar] [CrossRef]
- Camin, F.; Pavone, A.; Bontempo, L.; Wehrens, R.; Paolini, M.; Faberi, A.; Marianella, R.M.; Capitani, D.; Vista, S.; Mannina, L. The Use of IRMS, 1H NMR and Chemical Analysis to Characterise Italian and Imported Tunisian Olive Oils. Food Chem. 2016, 196, 98–105. [Google Scholar] [CrossRef] [PubMed]
- Palacios-Morillo, A.; Jurado, J.M.; Alcázar, Á.; de Pablos, F. Geographical Characterization of Spanish PDO Paprika by Multivariate Analysis of Multielemental Content. Talanta 2014, 128, 15–22. [Google Scholar] [CrossRef] [PubMed]
- Bona, E.; Marquetti, I.; Link, J.V.; Makimori, G.Y.F.; Arca, V.d.C.; Lemes, A.G.L.; Ferreira, J.M.G.; Scholz, M.B.d.S.; Valderrama, P.; Poppi, R.J. Support Vector Machines in Tandem with Infrared Spectroscopy for Geographical Classification of Green Arabica Coffee. LWT-Food Sci. Technol. 2017, 76, 330–336. [Google Scholar] [CrossRef]
- Diniz, P.H.G.D.; Gomes, A.A.; Pistonesi, M.F.; Band, B.S.F.; de Araújo, M.C.U. Simultaneous Classification of Teas according to Their Varieties and Geographical Origins by Using NIR Spectroscopy and SPA-LDA. Food Anal. Methods 2014, 7, 1712–1718. [Google Scholar] [CrossRef]
- Mandrile, L.; Zeppa, G.; Giovannozzi, A.M.; Rossi, A.M. Controlling Protected Designation of Origin of Wine by Raman Spectroscopy. Food Chem. 2016, 211, 260–267. [Google Scholar] [CrossRef]
- D’Archivio, A.A.; Giannitto, A.; Maggi, M.A.; Ruggieri, F. Geographical Classification of Italian Saffron (Crocus sativus L.) Based on Chemical Constituents Determined by High-Performance Liquid-Chromatography and by Using Linear Discriminant Analysis. Food Chem. 2016, 212, 110–116. [Google Scholar] [CrossRef]
- Etièvant, P.; Schlich, P.; Cantagrel, R.; Bertrand, M.; Bouvier, J. Varietal and Geographic Classification of French Red Wines in Terms of Major Acids. J. Sci. Food Agric. 1989, 46, 421–438. [Google Scholar] [CrossRef]
- Rizelio, V.M.; Gonzaga, L.V.; Campelo, S.; Maltez, H.F.; Carolina, A.; Fett, R. Fast Determination of Cations in Honey by Capillary Electrophoresis: A Possible Method for Geographic Origin Discrimination. Talanta 2012, 99, 450–456. [Google Scholar] [CrossRef]
- Lazaridis, D.G.; Karabagias, V.K.; Karabagias, I.K.; Andritsos, N.D.; Giannakas, A.E. Physicochemical and Phytochemical Characterization of Green Coffee, Cinnamon Clove, and Nutmeg EEGO, and Aroma Evaluation of the Raw Powders. Eur. Food Res. Technol. 2023, 250, 83–96. [Google Scholar] [CrossRef]
- Kitsios, A.-P.M.; Lazaridis, D.G.; Koutoulis, A.S.; Karabagias, V.K.; Andritsos, N.D.; Karabagias, I.K. Geographical Origin Estimation of Miniaturized Samples of “Nova” Mandarin Juice Based on Multiple Physicochemical and Biochemical Parameters Conjointly with Bootstrapping. Eur. Food Res. Technol. 2025. [Google Scholar] [CrossRef]
- Kokkosi, E.K.; Mylonaki, E.N.; Karabagias, V.K.; Andritsos, N.D.; Giannakas, A.E.; Karabagias, I.K. Shelf Life Extension of “Gyros’’ Pork Meat Using Plant Extracts with Antioxidant and Antimicrobial Activities. Food Biosci. 2024, 62, 105542. [Google Scholar] [CrossRef]
- Lazaridis, D.G.; Kokkosi, E.K.; Mylonaki, E.N.; Karabagias, V.K.; Andritsos, N.D.; Karabagias, I.K. Rapid Classification of Unroasted Green Coffee Beans and Spices Based on the Tentative Determination of Volatile Compounds by Solid-Phase Dynamic Extraction (SPDE) and Gas Chromatography–Mass Spectrometry (GC–MS) with Supervised Learning. Separations 2024, 11, 351. [Google Scholar] [CrossRef]
- Vanaki, E.; Kamkar, A.; Noori, N.; Azizian, A.; Mohammadkhan, F. The Effect of Aqueous Extract of Arctium lappa Root on the Survival of Lactobacillus Acidophilus La-5 and Bifidobacterium bifidum Bb-12 and Sensorial and Physicochemical Properties of Synbiotic Yogurt. Food Sci. Nutr. 2023, 12, 2182–2191. [Google Scholar] [CrossRef]
- Predes, F.S.; Ruiz, A.L.; Carvalho, J.E.; Foglio, M.A.; Dolder, H. Antioxidative and in Vitro Antiproliferative Activity of Arctium lappa Root Extracts. BMC Complement. Altern. Med. 2011, 11, 25. [Google Scholar] [CrossRef]
- Funaki, N.; Hattori, S.; Kimura, Y.; Sato, K.; Tsukada, M.; Tsumura, A.; Sano, M.; Toyoda, M.; Kozuka, K.; Kadokura, M.; et al. Determination of the Geographic Origin of Edible Burdocks by Inorganic Analysis. Nippon Shokuhin Kagaku Kogaku Kaishi 2010, 57, 70–77. [Google Scholar] [CrossRef]
- Hu, L.; Yin, C.; Ma, S.; Liu, Z. Tracing the Geographical Origin of Burdock Root Based on Fluorescent Components Using Multi-Way Chemometrics Techniques. Microchem. J. 2018, 137, 456–463. [Google Scholar] [CrossRef]
Disclaimer/Publisher’s Note: The statements, opinions and data contained in all publications are solely those of the individual author(s) and contributor(s) and not of MDPI and/or the editor(s). MDPI and/or the editor(s) disclaim responsibility for any injury to people or property resulting from any ideas, methods, instructions or products referred to in the content. |
© 2025 by the authors. Licensee MDPI, Basel, Switzerland. This article is an open access article distributed under the terms and conditions of the Creative Commons Attribution (CC BY) license (https://creativecommons.org/licenses/by/4.0/).